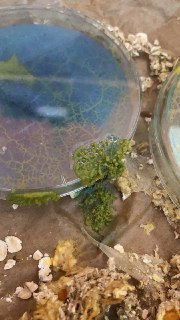

Can an organism establish a relationship with us?
Can an organism change our appreciation for the life around us?
Project summarized:
Everything around us is alive. The forest, the park, the river. Unfortunately, we often forget this far too quickly. We keep striving for simplicity and digitalization, but forget the living beings around us. With my project "An Intelligent Organism Changes Our Perception" I want to investigate if an Intelligent Organism can build an emotional bond with a human being and if this human being thereby values the nature around him more.
Background:
When I first saw Physarum, I was somewhat put off by its shape and color. The association (See part []) with my memories triggered (disgust, amazement, etc.). However, when I saw the first progress in the growth of Physarum, (See day...) this perception changed abruptly. Whenever I didn't see Physarum for a long time, I went as soon as possible to the place where it was stored and checked how it was doing. Exactly the same development I saw with my friend who was also a little bit deterred by Physarum at the beginning, but obviously got closer and closer. So she started to send photos and to look after him. This observation gave me the idea that at first we associate Physarum in our mind with negative terms and images, but with the time we took care of him, the emotional attachment and thus the appreciation towards an organism increased.
Why Physarum?
Why do I work with Physarum polycephalum and not with another slime mold or a mushroom in general? My thesis: "People form an emotional bond with Physarum because it is intelligent" may be true, but it is certainly not the only characteristic. So it is necessary to find a discriminating characteristic.
It seems rather unlikely that there is only one discriminating characteristic. I rather assume that the common occurrence of characteristics leads to an emotional bond.
To the intelligence:
First the question arises, how intelligence can be understood in connection with a slime mold. According to Prof. Döbereiner of the University in Bremen, intelligence should be expanded and understood as the ability to solve complex problems.
Physarum is not the only slime mold that is intelligent, there are numerous other slime molds that are considered intelligent, here is a list:
Google spits out when searching for "Intelligent Fungi" [Yes I know Physarum is not a fungus, I was just looking for other fungi species that could be Intelligent]. For the most part, Physarum out. It seems that this slime mold is a prototype of intelligent slime molds. In my opinion, intelligence is a characteristic that definitely strengthens the emotional bond with Physarum. However, since other slime molds are also "intelligent", intelligence cannot be the only reason. [What constitutes intelligence?]
Color: In our conversation with Miga, we were thinking about color. Basically, any kind of happening that stands out from the everyday world stays more in our memory and leaves a stronger impression. Ex:] If I see a clown on the street on a unicycle juggling, then this probably remains in our memory for a very long time. [ If you look for other slime molds, or mushrooms in general, you will notice that most of them have a less conspicuous color. I believe that the color of the slime mold definitely has an influence on the bond formation.
"Network?"
Behavior: The intelligence shows itself above all in the obvious behavior. The slime mold reacts to stimuli from the outside. Other slime molds also show this behavior, but Physarum shows this change relatively quickly.
Food: Another aspect is food. Physarum can feed on many things, here is a listing:
Oatmeal is often given with the meal. Sharing basically the same food with Physarum also has an influence on the formation of the bond, in my opinion.
How is the emotional bond measured?
The topic of the project deals with the emotional bond between an organism and a human being. Therefore it is important to measure this bond.
Now the question arises how emotions can be measured. I have read up a bit on the theory of testing and came up with the following possibilities:
One possibility would be the measurement with the help of magnetic resonance imaging. With these the activation of different emotional networks in the brain can be measured. Of course, I do not have the necessary tools for such tests. Another possibility would be the measurement by measuring facial expressions, but this is also not possible, because I am not with the persons the whole time. Another possibility would be questionnaires. Questionnaires bring some problems with them. They easily lead to bias and require a certain amount of introspection. With this type of quantitative method, the empirical data will obviously not be significant, but that is not too bad for this context. The type of scale I use is a Likert scale with pairs of opposites. However, I will combine this method with a qualitative interview to gain even deeper insights.
Structure of the toolkit:
What all should be included in the examination kit?
- Physarum
- dried sample
- Petri dishes
- oat flakes
- Agar agar
- questionnaires
- Information material (Basic)
- Information material advanced
My process
07 May:
Today I got two Petri dishes from the Biolab. One of them was empty, the other one contained an old Physarum.
When I arrived at home I cleaned the Petri dishes first. From dear Anna I got a sample of Physarum. (She also gave me a dried sample). After I cleaned the petri dishes, I watched the videos on how to cook medium. I have to honestly say that I am a little excited to grow my own organism. Of course, I read up on Physarum polycephalum on the internet. After that, I first watched the science fiction movie Blob - Horror without a Name.
Medium in the petri dishes (I was amazed how fast it solidifies).
To start simply I wanted to let my Physarum grow "normally" first. So I fed it with normal oatmeal and put it in my old fridge (this one doesn't cool anymore) overnight.
08.05:
The next morning I was very surprised to see that he had grown. It was very exciting to see the change. Pretty fast. It feels a little like taking responsibility for him.
I wondered if he would grow faster if it was warmer for him. I put him on the windowsill for that.
But it turned out that he grows best when he is in the dark refrigerator. I have wrapped the petri dishes in a cloth so that it is a little warmer.
08.05: I have now spread the oatmeal a bit so that Physarum grows in width.
09.05:
It turns out that he grows pretty fast and spreads out to get to his food.
Both samples are growing fast and you can see that he is starting to "eat" the other oatmeal piles. It is exciting to see Physarum spreading. Every morning after I got up, the first thing I did was check for Physarum. I have noticed that I have started to develop an emotional attachment to it. I take care of it and talk to it, even if that sounds strange. I give him food and have created a place for him to be. It feels good to take care of him.
09.05. Evening: It's crazy, it was a sunny day and I was outside the whole time. When I came back Physarum grew super fast.
Time for more space and a new home: Inspired by Anna, I wanted to create a bigger home for Physarum. For this, like Anna, I took a box and lined it with baking paper.
In the sunny weather I ate an ice cream. I then took the empty jar to grow Physarum in it. Now I could use the dried sample from Anna in the jar to see if already dried Physarum comes back to life.
Also, the labyrinths are now coming into use. I placed them in the big box and put oatmeal at the exits.
10.05:
I was very excited that the dried sample has grown. There has also been progress in the big box. Physarum has also grown in the maze. In the evening of the day Physarum it already almost managed to grow out of the maze.
11.05:
I no, when I looked after Physarum today, I saw that in the one sample in the petri dish it unfortunately started to mold, apparently there was too much moisture in the petri dish. Well - time for a new experiment: Now I wanted to try to feed Physarum with something unusual. For this I placed chips and sugar in the petri dish.
But also in the big box progress was shown. Physarum made it out of the maze.
Unfortunately, I forgot to put medium in the one maze, that's why Physarum didn't grow either... unfortunately.
12.05:
Ok that was fast! I looked in the fridge this morning to see how much Physarum has grown and I noticed that it has grown beyond the petri dish. I was a little surprised and also a little amazed that it's happening so fast after all. Pretty cool... But also with the chips something has happened, Physarum has grown over the one piece of the chips, but it doesn't really look like he likes it.
But things are also progressing quite a bit on the jar, as you can see Physarum has grown up the entire jar. I was a bit surprised, because there is no medium at these places.
Also in the box it goes forward, Physarum spreads more and more and is already much further than the labyrinth.
In the one Petri dish, it really takes off. The Physarum is growing over the edge. When I wanted to take it out of the refrigerator, I had to pull it off with some force so that it would detach from the refrigerator.
13.05:
Physarum continues to grow in the box as well.
14.05:
For an idea i thought it would be cool to colour the physarum. So i tooked some oat flakes and coloured them blue.
20.05:
Today there was a big progress, Physarum has turned green.
At the beginning when Physarum grew over the oat flakes, it did not change color. I was a little disappointed. But I thought I'd let it grow a bit and see what happened. But when Physarum grew out of the petri dish, it turned green. Then I was really happy.